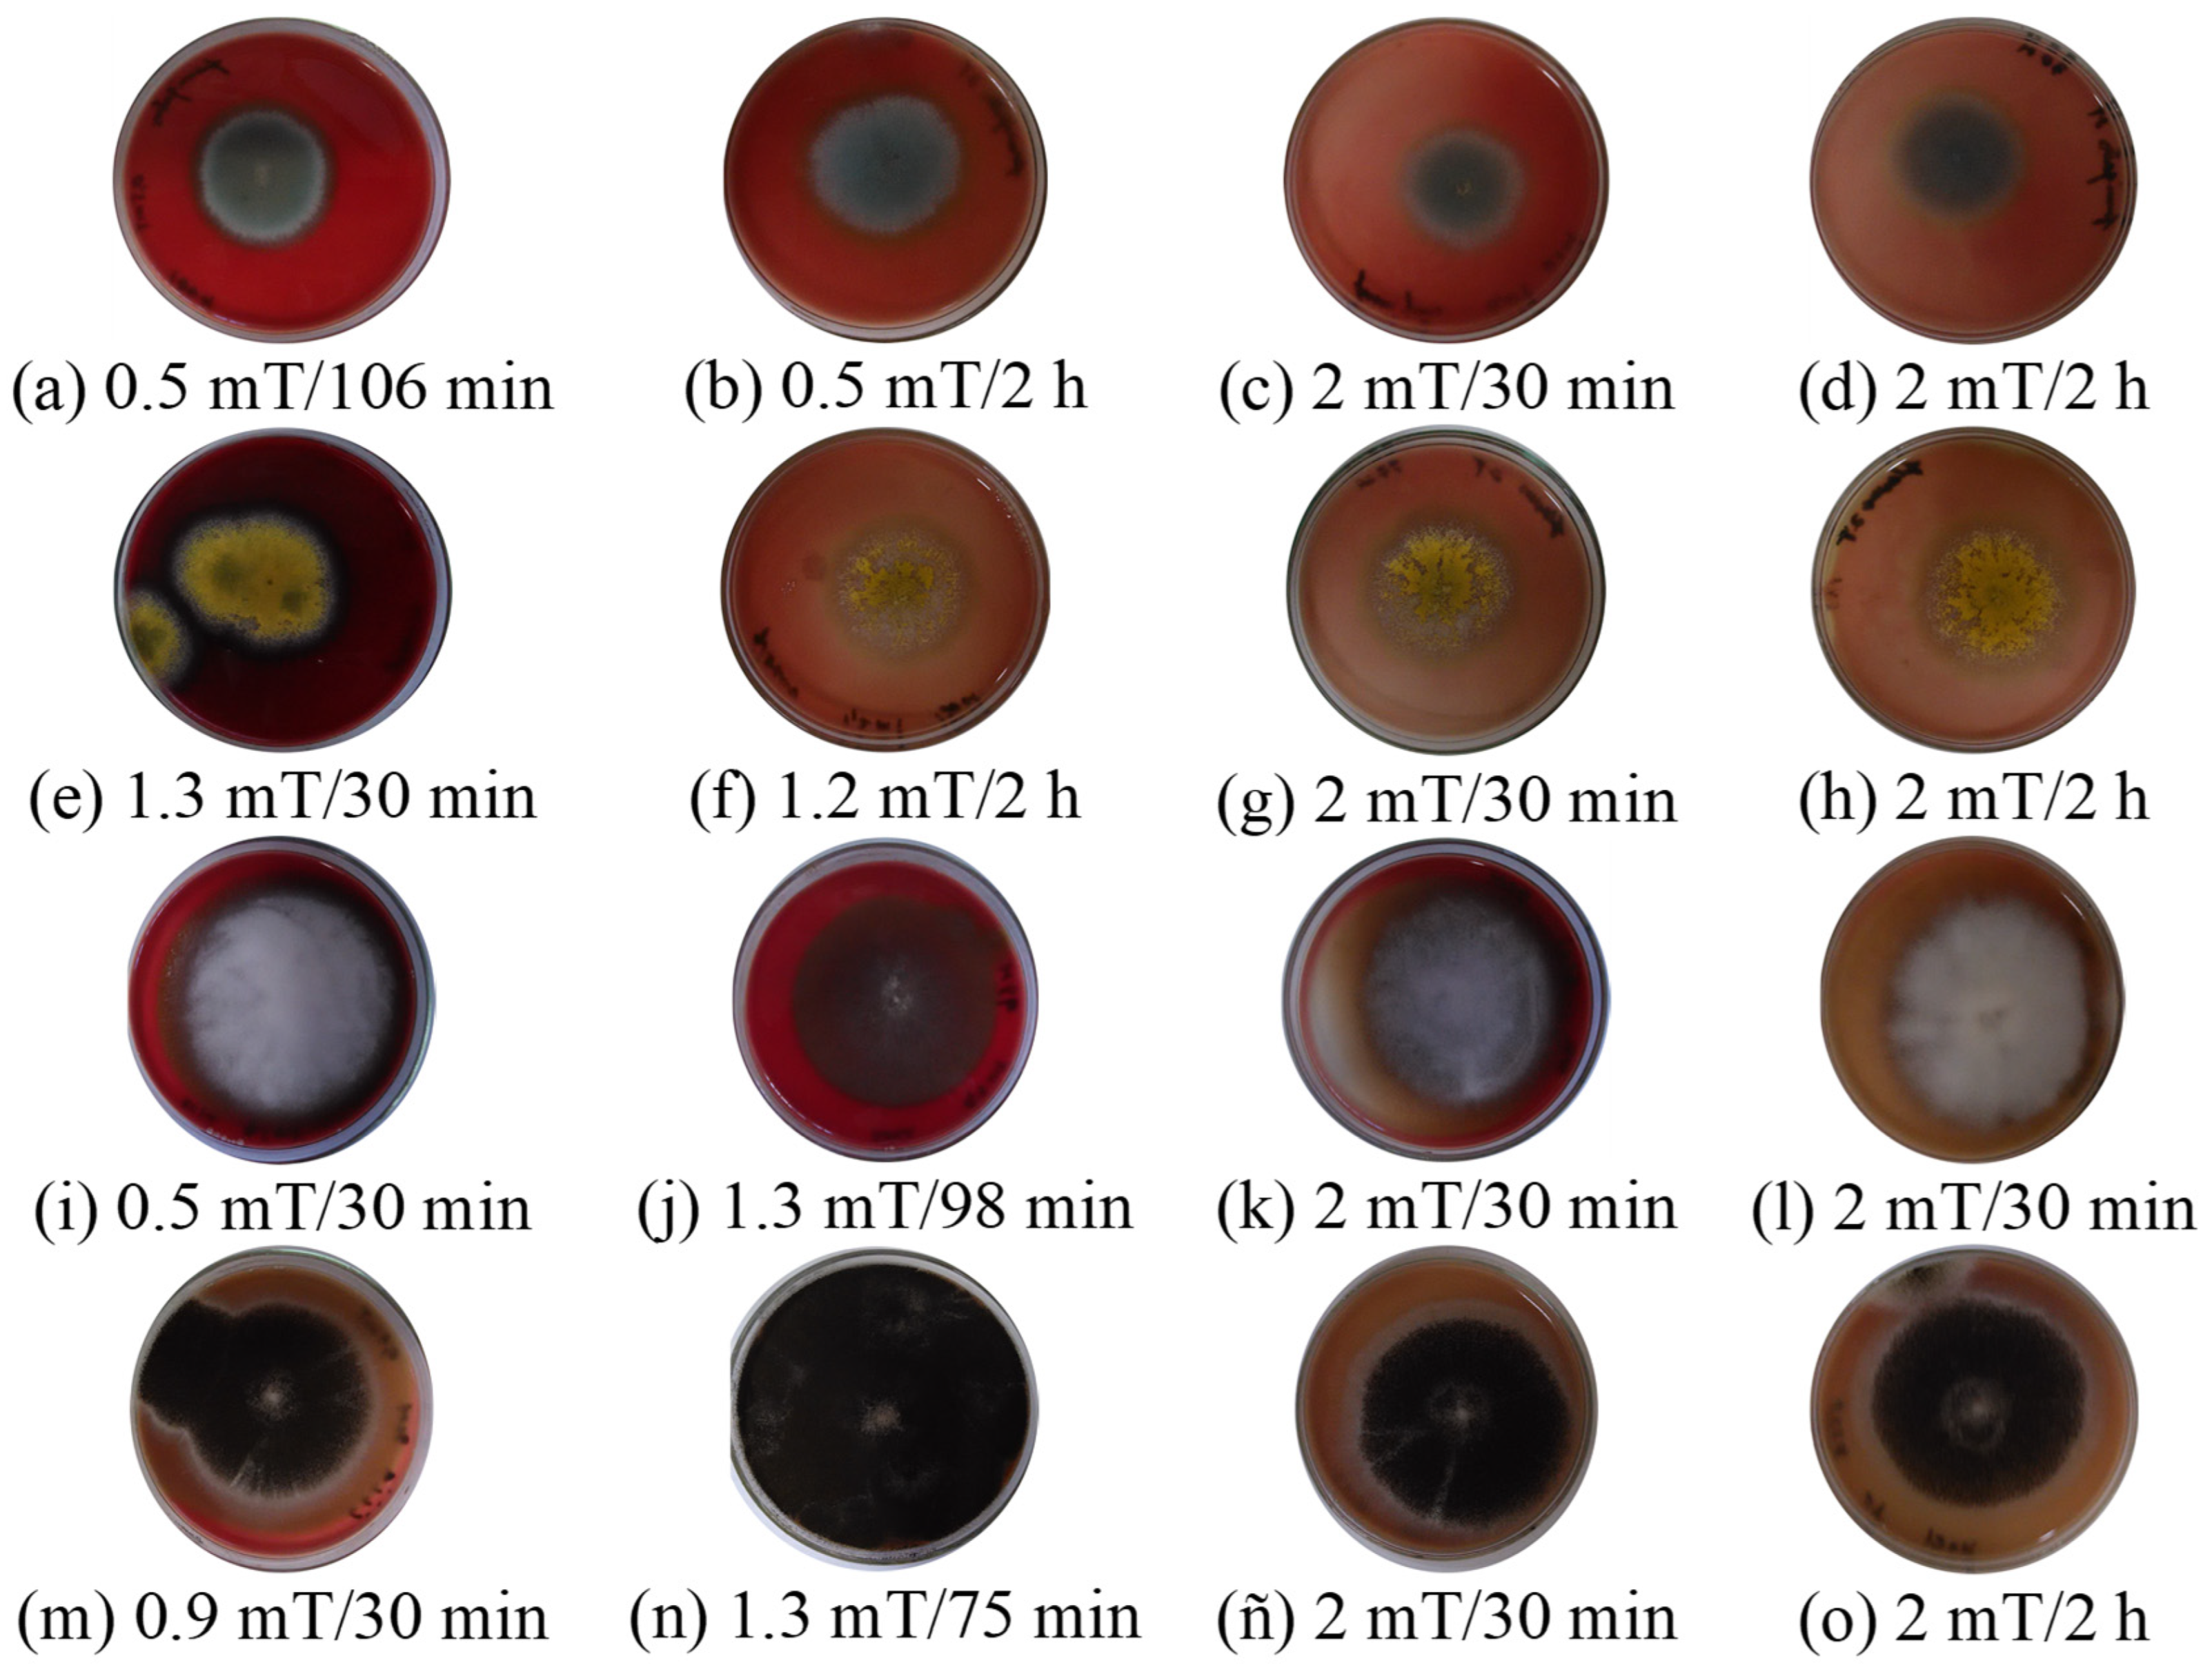
Aerobiology 03 00002 g006

Abstract
The aim of this study was to evaluate the effect of an extremely low-frequency oscillating magnetic field on the enzymatic activities of common airborne Aspergillus sp. strains that were isolated from indoor environments. A D-optimal experimental design with three factors was applied: magnetic field density (0.5 to 2 mT), exposure time (0.5 to 2 h), and Aspergillus sp. strains (A. ellipticus, A. japonicus, A. flavus, and A. fumigatus). The response variables were exoenzymatic indexes (cellulolytic, amylolytic, proteolytic, lipolytic, and hemolytic) and pH, as a measure of organic acid production. A. ellipticus was the highest producer of organic acids, and A. japonicus was as pathogenic as A. fumigatus. Different magnetobiological effects were observed: on enzyme secretion in the remaining strains, we detected no appreciable effect (Ilip and Iprot of A. flavus), inhibition (Ilip of A. ellipticus; Icel and Iamil of A. japonicus; Iamil and Iprot of A. fumigatus), and stimulation. Predictive quadratic models were obtained, and 2 mT for 2 h was the magnetic treatment regime that influenced the fungal enzymatic activity. These physiological changes following magnetobiological effects could be influenced during fungal sporulation and must thus be considered in aeromicrobiology studies. They can also be beneficial for obtaining industrial-use enzymes, but detrimental to the biodeterioration of different materials and human health.
1. Introduction
Numerous studies involving an extremely low-frequency oscillating magnetic field (ELF-OMF) on strains that were isolated from indoor environments [1,2,3,4,5] have concluded that it is a physical factor to consider in aeromicrobiology studies [6]. An ELF-OMF up to 50 or 60 Hz (alternating current) is classified as non-ionizing radiation, and its influence on airborne fungi in indoor environments is unknown. Also, the influence of the magnetic fields that are emitted by electronic appliances in indoor environments on airborne fungi must be taken into account in studies of air quality, the environment, and health [5].
In all these studies, fungal propagules were attracted and deposited on Petri dishes located near the ELF-OMF sources [1,2,3,4,5] because the spores of the fungus have an electric charge [6]. It is known that the effect of ionizing radiation on filamentous fungi is related to their nutritional status, and there are no genetic effects such as delay or stimulation in growth and enzyme activity, but the effect of non-ionizing radiation is unknown [5]. These studies have been supported by subsequent research [7,8] which suggested that the different observed magnetobiological effects on fungal strains are related to their degradative and pathogenic activities via protein secretion with enzymatic functions.
Thus, the question could be answered by proteomics, which is defined as the qualitative and quantitative comparison of proteins in a cell or organism under defined conditions at a given time point. In other words, proteomics is the term for a field that attempts to understand the expression, function, and regulation of the entire set of proteins that are encoded by an organism. Since the proteins within a cell are the functioning units, their expression is strongly influenced by environmental signals such as drugs, toxins, stress, age, and other surrounding conditions [9]. The environmental conditions at growth significantly influence the allergenicity of common fungi through the differential production of allergenic proteins and highlight the importance of in vivo or in vitro allergenicity measurements for understanding environmental exposure to airborne allergenic fungi. Numerous studies on sporulation and pathogenicity suggest that the environmental conditions during spore development result in physiological changes and differential gene expression in fungal spores. Since many fungal species, including A. fumigatus, have multiple unrelated allergenic proteins, environmental factors during sporulation may affect the regulation of genes encoding for these proteins, and therefore impact the per-spore allergenicity. In this sense, a 12-fold increase in A. fumigatus allergenicity per spore was observed when the sporulation temperatures were decreased from 32 °C to 17 °C. Despite the health significance of this potential link between environmental factors and human allergen exposure, the allergenicity of fungal spores that are produced under different environmental conditions has not been addressed [10].
These aforementioned studies were specifically performed on Aspergillus, one of the most frequently reported genera in studies on indoor air quality. This genus is amongst the 10 most cited fungal genera [11]. This one, similarly to a lot of fungi, is used because of its beneficial role in a vast range of applications, such as the production of several enzymes and pigments, applications in the food and pharmaceutical industries and the environmental and research domains, and the mitigation of the negative impacts of fungi (secondary metabolite production; etiological agents of diseases in plants, animals, and humans; and deteriogenic agents) [12]. The majority of fungal allergens are proteins [13], and environmental factors may impact the quantity and allergenic properties of airborne fungi [10].
Regarding enzyme production, the non-linear nature of enzymatic reactions and the large number of parameters that are involved have caused significant problems with respect to the efficient simulation of such reactions. Modeling transforms a real model into a mathematical model based on certain equations. The linearization of kinetic equations is a widely established practice for determining these parameters in enzyme catalysis, although it can often give misleading estimates, while the use of non-linear least squares fitting techniques is also regularly used, but can be unreliable when there are atypical values [14].
If it can be demonstrated that the same ELF-OMF regimen affects the enzymatic activity of several Aspergillus strains and the mathematical modeling of the optimal values can be adjusted, then it could be inferred that the extrapolation of the parameters will have certain benefits, whether due to a positive or negative effect on metabolism. Thus, to respond to this hypothesis, this study aimed to evaluate the effect of ELF-OMF on the enzymatic activities of common airborne Aspergillus sp. strains isolated from indoor environments.
2. Materials and Methods
2.1. Selection of Study Strains
Four strains of the genus Aspergillus P. Micheli ex Haller were selected: Aspergillus flavus Link, Aspergillus fumigatus Fresenius, Aspergillus ellipticus Raper and Fennell, and Aspergillus japonicus Saito.
The fungal colonies were identified based on morphological and cultural characteristics according to mycological manuals [15,16]. The scientific name of each taxon was verified using the MycoBank database (https://www.mycobank.org/ (accessed on 1 December 2024)).
All strains were isolated from indoor air samples from different premises and had a high surface growth rate in preliminary studies. Aspergillus fumigatus and A. ellipticus were isolated from a food warehouse, where they had the highest relative frequency of appearance [17]. Aspergillus japonicus, which exhibited a higher exoenzymatic activity than the others, was isolated from nearby aerobiota from sources emitting magnetic fields in indoor environments, and was also detected at a high relative density [18]. Aspergillus flavus was the most frequently observed species in aeromycological and biodeterioration studies [3].
2.2. Experimental Design
An experimental design was performed using the statistical software Design Expert ver. 8.0.1.0 (Stat-Ease, Arden Hills, MN, USA). This statistical software outputs a matrix with different values (between low and high values and its replicate). In total, 25 experimental runs were conducted randomly through a multifactorial D-optimal analysis with 3 factors (Table 1).
Table 1.
Factors used in the experimental design.
The low and high values of ELF-OMF were selected from previous studies, and were the optimal values in experimental runs with factors between 5 and 120 min (2 h) and 0.3 to 10 mT [1,2,3,4,5,7,8], measuring 2 mT at the fifth part in the minor extreme of this range. The response variable was the exoenzymatic index that allowed us to analyze and predict the behavior of the mathematical models, if they were adjusted.
2.3. Magnetic Treatment
The ELF-OMF treatments were applied with the same equipment as in the above-mentioned studies [1,2,4,7,8]. This experimental equipment was designed and manufactured by Electronic Technologies (ETEC, Pinar del Río, Cuba) and characterized by the National Center of Applied Electromagnetism (NCAE) located in Santiago de Cuba, Cuba. The equipment consisted of a signal generator of an electrical current (60 Hz/220 V) and a solenoid-type cardboard coil (with an air core) 30 cm in diameter and 29 cm in height. Its wire was made of copper (2 mm in diameter) for 6.1 Ω of resistance. The ELF-OMF was controlled by the signal generator.
In each study, the fungal strain was inoculated on a Petri dish with an appropriate culture medium, as will be described in the next section. Control samples that did not receive magnetic treatment and ELF-OMF were applied immediately after inoculation. Petri dishes with the study strains were placed in the coil center, remaining there according to the conditions described in the experimental design (Figure 1).
Figure 1.
Representative diagram of magnetic treatment. (A) Layout of the experimental design; (B) module surface and magnetic induction lines of the equipment.
For the performance, the intensity of the electrical current (ampere) from the equipment was graduated to the same ELF-OMF density of each run of the experimental design, and all Petri dishes with the same strains were placed at the same time. Then, they were removed at the indicated time and incubated under the same conditions for the determination of each one’s enzymatic activity.
2.4. Determination of Enzymatic Activity
Strains were conserved in slants of Malta Extract Agar, covered with mineral oil, and kept refrigerated at 4 °C. They were activated in an Erlenmeyer flask with malt extract agar, where they were incubated for 7 days. Then, 10 mL of sterile distilled water was added and gently shaken to remove the fungal spores from the culture. The spore suspension was evaluated in a Neubauer chamber to determine the concentration of spores at which worked, following the methodology described in the literature [19]. From the spore solution obtained (106 spores/mL), 10 µL was inoculated in each Petri dish, and the physiology of the fungal strains was determined by the following techniques to determine their enzymatic activities [3,20,21,22,23]:
To determine cellulolytic activity, the strains were seeded in a Petri dish with the culture medium of the following composition per liter: sodium nitrate, 2 g; dipotassium phosphate, 1 g; magnesium sulfate, 0.5 g; potassium chloride, 0.5 g; ferrous sulfate, 0.01 g; agar, 20 g; and pH 5.5. As a control, glucose (1%) and carboxymethylcellulose (1%) were used as a sole carbon source. The cultures were incubated at 30 °C for 21 d. Subsequently, Congo red (0.05 g/L) was added to each of the dish for one hour, the solution was decanted, and finally 1 molar NaCl was added for 10 min. Cellulolytic activity was evidenced by the formation of a white halo around the colony [3,21,22,23].
Acid production: Spore suspensions from each fungal isolate were seeded in a liquid minimal medium of composition identical to the one described above, but glucose at 1% was the carbon source, and the pH was adjusted to 7. Phenol red (0.001%) was added as an indicator-of-change color. The cultures were incubated at the same temperature for 3 days before we measured the pH of the culture medium with a potentiometer [3,20,22].
Proteolytic activity: This determination was carried out by means of gelatin hydrolysis assays. Each strain was seeded on a Petri dish containing a gelatin culture medium. The composition of the medium was similar to that of the cellulolytic assay, but without agar and with 5 g/L of gelatin as the only carbon source. After 7 days of incubation at 30 °C, Frazier’s reagent was added. A white precipitate around the colony indicates the presence of non-hydrolyzed gelatin, and the absence of this, that is, a colorless halo, shows the hydrolysis of the gelatin [3,21,22,23].
Amylolytic activity: Each strain was streaked on a Petri dish containing a minimal medium identical to the one described above containing starch (5 g/L) as the sole carbon source. After 7 days of incubation at 30 °C, we added 5 mL of Lugol’s reagent over each culture plate, and the presence of a colorless zone around the fungal colonies was taken as an indication of positive hydrolysis [3,21,22,23].
Hemolytic activity: The strains isolated were seeded in Petri dishes with Czapek Dox agar (BIOCEN, Bejucal, Mayabeque, Cuba) supplemented with defibrinated sheep blood at 5 and 0.5% chloramphenicol [22,23]. They were incubated at 37 °C for 24 to 48 h. The pathogenicity was evidenced by the appearance of a halo around the colony indicating partial hemolysis if the halo was green (alpha hemolytic), and total hemolysis if it was colorless (beta hemolytic), and an absence of hemolysis if there was no halo (hemolytic gamma) [23,24].
Lipolytic activity: The fungal strains were inoculated in Petri dishes which contained culture medium, Agar (1%), Peptone (1%), CaCl2 (0.1%), NaCl (0.5%), Chloramphenicol (0.05%), and the surfactant Tween 80 (1%). They were incubated at 28 °C for 10 days. Then, lipolytic activity indicated by a white halo was observed surrounding the colony [3,21,22].
2.5. Exoenzymatic Index
After, enzymatic activity was obtained using semiquantitative methods, indicating both degradative (acid production and cellulolytic, proteolytic, and amylolytic activities) and pathogenic activities (lipolytic and hemolytic activities). The exoenzymatic index was calculated as the difference between the diameter of the colonies and the diameter of the halo or the colorless zone in Petri dishes according to the following general equation [23]:
where I is the index of activity of the enzyme and Dc and Dh are the diameters of the colony and halo (cm), respectively.
When there were no variations in the exoenzymatic indexes of these enzymes compared to treated ones, the results were reported as “no appreciable effects”, and increased or decreased values were reported as “stimulation” or “inhibition”, respectively.
2.6. Statistical Analysis
The assays were conducted in triplicate. The results were analyzed with Statgraphics Centurion XV using a Student’s t-test for 95% confidence (p < 0.05). To determine the significance of the effect induced by ELF-OMF applied, a multifactorial analysis of variance (MANOVA) and multiple range method by the least significant difference (LSD) were conducted. The 25 experimental runs were performed randomly with the mean values of the exoenzymatic indexes (the first four columns in Table 2).
Table 2.
Experimental matrix with results of ELF-OMF treatment on Aspergillus sp.
3. Results
Table 2 shows the results of the experimental runs with mean values (n = 3). Runs 3, 4; 9, 10; 13, 14, and 20 to 23 are replicated, which allowed us to adjust the model.
The exoenzymatic index was effective for evaluating the ELF-OMF effect on the enzymatic secretion of the studied strains (Figure 2). The values obtained by this technique had a normal distribution (p ≤ 0.05), allowing the sample means to be taken as the population mean. Figure 3 and Figure 4 present the control strain values and the maximum value of the evaluated treatment (2 mT for 2 h) to support the discussion of the phenomenon observed.
Figure 2.
Exoenzymatic activity (culture media) of A. flavus using semiquantitative methods.
Figure 3.
Exoenzymatic indexes of Aspergillus sp. strains treated with ELF-OMF.
Figure 4.
Organic acid production in Aspergillus sp. strains treated with ELF-OMF.
All control strains (0 mT) had exoenzymatic index mean values above 0.5, indicating high degradative and pathogenic activity (Figure 3). The highest indexes were obtained with A. flavus and A. japonicus, and this was latter noted for Icel = 0.62 and Iamil = 0.56. The A. flavus strain presented Iprot = 0.58. It is noteworthy that the lipolytic activities of each strain were similar (Ilip = 0.51), and A. fumigatus and A. japonicus exhibited Ihem = 0.55.
The studied control strains can be classified as low organic acid producers since the mean pH was between 5.9 and 6.3 (Figure 4). However, applying an ELF-OMF of 2 mT increased the production of these compounds due to a decrease in the culture medium pH. A. ellipticus was the predominant organic acid producer (pH = 5.4).
After applying the magnetic treatment (Table 2; Figure 3 and Figure 4), different magnetobiological effects were observed. For example, no appreciable effect (Ilip and Iprot of A. flavus), inhibition (Ilip of A. ellipticus, Icel and Iamil of A. japonicus; Iamil and Iprot of A. fumigatus), or stimulation of enzyme secretion was detected in the rest of the strains.
Although there was no appreciable effect on Ilip of A. flavus or inhibition on Ilip of A. ellipticus, all treated strains showed stimulation of this exoenzymatic index and Ihem (d and e in Figure 3). These were interesting results because both indexes are indicative of pathogenic activities.
The inhibition of enzymatic secretion was observed by the reduced colony diameter of the A. japonicus strain (Figure 5). This morphological effect was also observed in the hemolysis test at 25 °C, with a marked impact on their shape and the pigmentation of the colony (Figure 6).
Figure 5.
Amylolytic activity of A. japonicus on 90 mm Petri dishes. (a) Control; (b) 2 mT for 2 h; and (c) 0.5 mT for 2 h. After ELF-OMF, it was incubated at 25 °C/7 days. Note: the white color is the halo of the fungal colony (at center) and the surround dark color is the culture media stained by Lugol’s reagent.
Figure 6.
Hemolytic activity on 90 mm Petri dishes. A. fumigatus (a–d); A. flavus (e–h); A. japonicus (i–l); and A. ellipticus (m–o). After ELF-OMF, incubated at 25 °C/7 days.
However, increased hemolytic activity was evidenced by erythrocyte lysis in the culture medium, which is in line with the increased ELF-OMF density and exposure time. This can be noted with the increase in pigmentation of the colony at the time of the culture medium color changing (change from red to pink). Therefore, of all treated strains, the greatest stimulation was observed with 2 mT for 2 h (Figure 6d,h,l,o).
Factor A was the only one not significant (p ≥ 0.05) in the effects of the ELF-OMF treatment applied on any Aspergillus sp. fungal strains and to the rest factors, and their interactions were different (Table 3). This behavior can be predictive when the factors have significance (p ≤ 0.05) in the evaluated response variables (in this case, Icel, Iamil, and Ilip), and if they also have significance in the mathematical modeling (Table 4).
Table 3.
Significance of each factor to adjust the mathematical models of D-opt design.
Table 4.
Adjusted mathematical models of D-opt design.
Table 4 shows the adjusted mathematical models (y = X0.A2 + X1.B2 + X2.AB + X3.B + X4). The Icel, Iamil, and Ilip were adjusted to quadratic models (R2 from 0.6975 to 0.9167), indicating the optimal values of ELF-OMF density and time for the maximum effect on the response variables. The Iprot, Ihem, and pH were adjusted to mathematical models, but were not significant (p ≥ 0.05), so they do not allow for predicting these variables’ behavior due to the ELF-OMF and time course effects.
The results from Table 4 highlight that the exposure time effect of ELF-OMF (A) and its interaction with the density values (AB) and its quadratic term (A2) indicated proximity to the optimal value of superficial growth. Additionally, the factor (A2) was more stimulatory for Iamil (0.05) than inhibitory for Icel (−0.01). For ELF-OMF density values (B), it was stimulatory for Icel and Iamil, termed both B and B2, considering, respectively, the positive signs of B (0.06 to 0.13) were higher than the negative sign (−0.04), being more significant for A. ellipticus given the higher coefficient value (0.13).
The cellulolytic index increased from 1 h to 2 h, reaching the maximum value with ELF-OMF density close to 1.70 mT to 2 mT (Figure 7a). Similarly, the maximum amylolytic index was reached in 2 h with 2 mT (Figure 7b). Note the coincidence of the maximum values of the cellulolytic, amylolytic, and lipolytic indexes for 2 h, although the latter was obtained with 0.50 mT (Figure 7c).
Figure 7.
Response surfaces obtained from the D-optimal experiment for the exoenzymatic indexes of Aspergillus sp. strains adjusted to quadratic mathematical models. (a) Cellulolytic; (b) amylolytic; and (c) lipolytic.
4. Discussion
The semiquantitative nature of the exoenzymatic index facilitated the effectiveness of evaluating magnetobiological effects in this study, demonstrating that this method can make non-subjective inferences about enzyme secretion and organic acid production [3]. This is an advantage over traditionally used qualitative methods.
The control strains with the highest exoenzymatic index were A. flavus and A. japonicus. They had high degradative power on cellulose, starch, and gelatin. Evaluating these strains confirmed that Aspergillus sp. is a genus with a strong exoenzymatic complex. This is in accordance with the results obtained by other authors [25,26], highlighting that the genus is one of the fungi with the greatest lipolytic activity [27].
However, this variation in effects was also observed in similar studies which reported that the ELF-OMF had a different active effect on spores and filamentous fungi degrading various polymer materials by fungal oxidoreductase action, with both increased and decreased enzymatic activities. But the maximum catalase activity was found in Aspergillus sp. [28]. Although fungal spores found indoors originate from fungi that might have grown inside buildings on moist surfaces [29], and the magnetic fields have effects on water molecules and other biological macromolecules (such as of proteins, carbohydrates, and lipids) [30], as a limitation by the design of this study, it is necessary to highlight that it is unknown whether the growth of Aspergillus sp. on culture media (in controlled conditions) will respond in the same way to an ELF-OMF as actual growth on various indoor surfaces with different compositions to the controls would.
With respect to inhibition results, the cellulolytic activity of A. japonicus agrees with the inhibitor effect in the carboxymethylcellulose activity of Aspergillus niger by an ELF-OMF of 50 Hz (10 mT by 2 h) [31]. But the decrease in culture medium pH (which increases acidity) after ELF-OMF can be attributed to the stimulation of enzyme secretion and increased organic acid production. This result could be applied in magnetic catalysts based on iron oxides [32].
In this study, the stimulation of proteolytic activities of A. ellipticus and A. japonicus was not significant, but was consistent with similar activity under static magnetic fields (SMFs) with no frequency (0 Hz), where acid protease activity increased to 91.4% compared with the control, A. niger [33]. An ELF-OMF of 2 GHz increased the α-amylase 1.5- to 3-fold higher than the control sample of Aspergillus oryzae [34], while the effect of SMF amylase activity decreased and protease activity was non-significant when compared to A. niger as a control [35].
The highest hemolytic activity stimulation was observed with 2 mT and 2 h. These conditions likely favor the synthesis and secretion processes of hemolysins, which relates to their pathogenicity as fungal toxins. This is similar to the effects on the concentration of total aflatoxin of A. flavus by SMFs obtained by magnets, which was applied through a magnet at different forces (5, 7, 10, 30, and 50 Gauss (G) (1 mT = 10 G)) for seven days at a temperature of 27 °C [36]. It is also in agreement with other pathogenic fungal strains: Magnaporthe oryza under 50 Hz ELF-OMF (3 mT) enhanced its infection capacity [37], and Candida albicans under 50 Hz ELF-OMF (35 mT for 24 h) contributed to membrane permeabilization and did not inhibit the transformation of the yeast to its hyphal form, making this is an antifungal therapy that may emerge as a new option to support the treatment of these yeast infections, due to the plasticity of the mycelial form being a determining factor of drug resistance, as well as an important factor in the infection phase [38].
These results align with studies conducted with an ELF-OMF between 2 and 5 mT applied to this strain, A. niger, Cladosporium cladosporioides, and Penicillium chrysogenum in different culture media [5].
In this respect, the non-appreciable effects on enzyme secretion may be due to the ELF-OMF density and exposure time not being sufficient to modify the corresponding secretory biosynthetic pathway of the strain in question. In cases where stimulation was observed, it is likely that enzyme synthesis was favored, secretion vesicles increased in number, or cytoskeletal elements facilitated their arrival at the plasma membrane. These processes should occur inversely in cases where enzyme secretion is inhibited. All these particularities also depend on the fungal strain in question. However, these elements are not published in the scientific literature, requiring further studies with advanced techniques to verify this new hypothesis [30,39,40,41].
Finally, the quadratic models obtained were within the applied factors between 1 and 2 mT. The statistical significance of the exposure time to ELF-OMF (A) coincides with those observed in studies with this physical factor [1,4,5,7]. For example, by 2 h of exposure time, the obtained results fit a quadratic model (y = ax2 + bx + c) that predicts 98% of the behavior of the variable (R2 = 0.98), according with the equation Dc = X0.B2 + X1.B + X2.A + X3, where Dc = diameter of fungal colony; X0, X1, and X2 are the regression coefficients; X3 is the constant model; A is the density of the ELF-OMF (1 to 5 mT); and B is the incubation time of the fungal strain (7 d) [5]. This result for the stimulation of fungal metabolism by an ELF-OMF (non-ionizing radiation) can be described with a general exponential equation of the form Y = m.xk [7], which agrees with what was observed for ionizing radiation (space radiation), obtained in this study with a linear model of the form Y = m.x + c [42]. For both cases, “x” is the time, and “Y” in the first one is the superficial growth of the fungus in the Petri dishes, while in the second one it is the accumulated radiation counts of the fungus during its growth. And, by the linearization of the exponential equation, we can find the exponent k value.
The adjustment of Icel, Iamil, and Ilip to significant quadratic models may be due to the ease these strains have in degrading simpler molecules such as cellulose, starch, and lipids compared to more complex molecules like those present in the blood (erythrocyte plasma membrane) and gelatin. This is similar to the non-linear adjustment of the cellulase production parameters by a strain of Aspergillus niger in solid fermentation, which is reported [14].
This suggests that, at low frequencies and densities, the ELF-OMF is a physical factor with a greater effect than the SMF on enzymatic activity. Also, a common response to radiation on fungal strains could be inferred. But more studies are required to define the biological mechanisms for these physiological changes induced by magnetobiological effects.
5. Conclusions
With the results of this study, the authors cannot know what will happen outside of the settings applied, but the ELF-OMF can stimulate or inhibit enzymatic secretion and organic acid production in common airborne A. ellipticus, A. flavus, A. japonicus, and A. fumigatus, affecting their degradative and pathogenic activities. This effect can be beneficial for obtaining industrial-use enzymes, but detrimental to the biodeterioration of different materials and human health.
This result suggests that when conducting biomagnetism studies with Aspergillus sp. strains, a single time value should not be applied for a given treatment. It is recommended to use several time values and analyze their relationship with other factors, such as the interaction with the fungal strain in question. Although 2 mT for 2 h is the magnetic treatment regime with the greatest influence, an ELF-OMF should be considered for future aeromicrobiological studies and its effects on filamentous fungi.
Mathematical modeling performed with the optimal values of the factors in ELF-OMF treatment obtained before in several studies on fungal metabolism has allowed us to adjust a quadratic model in this study on enzymatic activities. This can be expressed by a general exponential equation, which suggests a common response to the magnetobiological effects observed using the same biological mechanism as the radiation in relation to proteomics.
Author Contributions
M.A.-V.: Conceptualization, Methodology, Investigation, Validation, and Writing—original draft. E.G.-E.: Data curation, Formal Analysis, Methodology, Investigation, and Writing—original draft. S.B.-A.: Methodology, Investigation, Supervision, and Writing—review and editing. All authors have read and agreed to the published version of the manuscript.
Funding
This research received no external funding.
Institutional Review Board Statement
Not applicable.
Informed Consent Statement
Not applicable.
Data Availability Statement
The data supporting the outcome of this research work have been reported in this manuscript.
Conflicts of Interest
The authors declare no conflicts of interest.
References
- Anaya, M.; Castro, M.; Borrego, S.; Cobo, H. Influencia del campo magnético sobre la distribución de los hongos en el aire de un local cerrado. Rev. De La Soc. Venez. De Microbiol. 2015, 35, 47–52. [Google Scholar]
- Anaya, M.; Barbará, E.; Padrón, J.; Borrego, S.; Valdés, O.; Molina, A. Influencia del campo magnético sobre el crecimiento de microorganismos patógenos ambientales aislados en el Archivo Nacional de la República de Cuba. Biomédica 2015, 35, 325–336. [Google Scholar] [CrossRef] [PubMed]
- Anaya, M.; Borrego, S.; Gámez, E.; Castro, M.; Valdés, O.; Molina, A. Viable fungi in the air of indoor environments of the National Archive of the Republic of Cuba. Aerobiologia 2016, 32, 513–527. [Google Scholar] [CrossRef]
- Anaya, M.; Borrego, S.; Castro, M.; Valdés, O.; Molina, A. Influence of the 60 Hz magnetic field on the airborne microbial distribution of indoor environments. J. Atmos. Sci. Res. 2020, 03, 23–32. [Google Scholar] [CrossRef]
- Anaya, M.; Gámez, E.; Valdés, O.; Guzmán, T.; Borrego, S. Effect of the oscillating magnetic field on airborne fungal. Arch. Microbiol. 2021, 203, 2139–2145. [Google Scholar] [CrossRef]
- Anaya, M.; Borrego, S.; Castro, M. Considerations about the influence of extremely low frequency oscillating magnetic field on indoor airborne. Rev. CENIC Cienc. Biol. 2021, 52, 079–092. [Google Scholar]
- Anaya, M.; Borrego, S.; Barbará, E. Quantification of superficial growth and the pigmentation of filamentous fungi by effect of oscillating magnetic field. Rev. CENIC Cienc. Biol. 2022, 53, 126–139. [Google Scholar]
- Anaya, M.; Gámez, E.; Borrego, S.; Barbará, E. Magnetotropism: A tropic response of Candida guillemondii by the effect of the oscillating magnetic field of extremely low frequency. Air Qual. Atmos. Health 2023, 16, 2367–2376. [Google Scholar] [CrossRef]
- Razzazi, E.; Rizwan, M.; Mayrhofer, C.; Nöbauer, K. Chapter 7: The use of proteomics as a novel tool in aflatoxin research. In Aflatoxins. Biochemistry and Molecular Biology; InTechOpen: London, UK, 2011; pp. 127–150. [Google Scholar]
- Swee, Y.L.; Dannemiller, K.; Yao, M.; Yamamoto, N.; Peccia, J. The allergenicity of Aspergillus fumigatus conidia is influenced by growth temperature. Fungal Biol. 2011, 115, 625–632. [Google Scholar] [CrossRef]
- Bhunjun, C.; Phukhamsakda, C.; Boekhout, T.; Groenewald, J.; McKenzi, E.; Francisco, E.; Frisvad, J.; Groenewald, M.; Hurdeal, V.; Luangsa-Ard, J.; et al. What are the 100 most cited fungal genera? Stud. Mycol. 2024, 108, 1–412. [Google Scholar] [CrossRef]
- Corbu, V.M.; Gheorghe-Barbu, I.; Dumbravă, A.S.; Vrâncianu, C.O. Current insights in fungal importance. A comprehensive review. Microorganisms 2023, 11, 1384. [Google Scholar] [CrossRef] [PubMed]
- Stewart, G.A.; Robinson, C. Indoor and outdoor allergens and pollutants. In Middleton’s Allergy Essentials; Elsevier: Amsterdam, The Netherlands, 2017; pp. 73–116. [Google Scholar] [CrossRef]
- Maisincho, M.P.; Delgado, M.H.; Cedeño, C.A. Modelos matemáticos en la cinética enzimática. Una revisión. Rev. Cent. Azúcar 2022, 49, 115–131. Available online: http://scielo.sld.cu/pdf/caz/v49n1/2223-4861-caz-49-01-115.pdf (accessed on 10 November 2024).
- Klich, M.A.; Pitt, J.I. A Laboratory Guide to the Common Aspergillus Species and Their Teleomorphs; Commonwealth Scientific and Industrial Research Organization: Canberra, Australia, 1994; 116p. [Google Scholar]
- Simões, M.F.; Santos, C.; Lima, N. Structural diversity of Aspergillus (section Nigri) spores. Microsc. Microanal. 2013, 19, 1151–1158. [Google Scholar] [CrossRef] [PubMed]
- Anaya, M.; Borrego, S.; Cobo, H.; Valdés, O.; Molina, A. Aeromicobiota de un depósito de alimentos en La Habana, Cuba. Augmdomus 2014, 6, 95–110. [Google Scholar]
- Anaya, M.; Gámez, E.; Falco, A.S.; Benítez, E.; Carballo, G. Characterization of indoor air mycobiota of two locals in a food industry, Cuba. Air Qual. Atmos. Health 2019, 12, 797–805. [Google Scholar] [CrossRef]
- Araujo, R.; Rodríguez, A.G.; Pina-Vaz, C. A fast, practical and reproducible procedure for the standardization of the cell density of an Aspergillus suspension. J. Med. Microbiol. 2004, 53, 783–786. [Google Scholar] [CrossRef]
- Borrego, S.; Guiamet, P.; Gómez de Saravia, S.; Batistini, P.; Garcia, M.; Lavin, P.; Perdomo, I. The quality of air at archives and the biodeterioration of photographs. Int. Biodeterior. Biodegrad. 2010, 64, 139–145. [Google Scholar] [CrossRef]
- Borrego, S.; Lavin, P.; Perdomo, I.; Gómez de Saravia, S.; Guiamet, P. Determination of indoor air quality in archives and the biodeterioration of the documentary heritage. ISRN Microbiol. 2012, 2012, 680598. [Google Scholar] [CrossRef]
- Borrego, S.; Molina, A. Behavior of the cultivable airborne mycobiota in air-conditioned environments of three Havanan archives, Cuba. J. Atmos. Sci. Res. 2020, 3, 16–28. [Google Scholar] [CrossRef]
- Bogomolova, E.; Kirtsideli, I. Airborne fungi in four stations of the St. Petersburg underground railway system. Int. Biodeterior. Biodegrad. 2009, 63, 156–160. [Google Scholar] [CrossRef]
- Llop, A.; Valdés, D.; Vivanco, M.M.; Zuazo, J. Microbiología y Parasitología Médica, 3rd ed.; Ciencias Médicas: Havana, Cuba, 2001; Volume 1. [Google Scholar]
- Abdel-Azeem, A.M.; Abdel-Azeem, M.A.; Abdul-Hadi, S.Y.; Darwish, A.G. Aspergillus: Biodiversity, Ecological significances, and industrial applications. In Recent Advancement in White Biotechnology Through Fungi. Fungal Biology; Yadav, A., Mishra, S., Singh, S., Gupta, A., Eds.; Springer: Cham, Switzerland, 2019. [Google Scholar] [CrossRef]
- Veselská, T.; Homutová, K.; Fraile, P.G.; Kubátová, A.; Martínková, N.; Pikula, J.; Kolařík, M. Comparative eco-physiology revealed extensive enzymatic curtailment, lipases production and strong conidial resilience of the bat pathogenic fungus. Pseudogymnoascus destructans. Sci. Rep. 2020, 10, 16530. [Google Scholar] [CrossRef]
- Amaya, O.J.; Díaz, A. Caracterización de hongos productores de enzimas lipasas. Cienc. E Ing. 2022, 9, e6708445. [Google Scholar] [CrossRef]
- Makarov, I.O.; Llyuev, D.D.; Smirnov, V.F. Effect of low frequency pulsed magnetic field and low-level laser radiation on oxidoreductase activity and growth of fungi-active destructors of polymer materials. Microbiology 2019, 88, 72–78. [Google Scholar] [CrossRef]
- Knutsen, A.P.; Bush, R.K.; Demain, J.G.; Denning, D.W.; Dixit, A.; Fairs, A.; Greenberger, P.A.; Kariuki, B.; Kita, H.; Kurup, V.P.; et al. Fungi and allergic lower respiratory tract diseases. J. Allergy Clin. Immunol. 2012, 129, 280–291. [Google Scholar] [CrossRef] [PubMed]
- Li, W.; Haile, M.; Ronghai, H.; Xiaofeng, R.; Zhou, C. Prospects and application of ultrasound and magnetic fields in the fermentation of rare edible fungi. Ultrason. Sonochem. 2021, 76, 105613. [Google Scholar] [CrossRef]
- Aboneima, S.M.; El-Metwally, M. Effect of extremely low frequency magnetic field in growth, CM case, electric conductivity and DNA of Aspergillus niger. Egypt. J. Phys. 2021, 49, 15–34. [Google Scholar] [CrossRef]
- Escobaro, A.M.; Pizzioa, L.R.; Romanelli, G.P. Catalizadores magnéticos basados en óxidos de hierro: Síntesis, propiedades y aplicaciones. Cienc. En Desarro. 2019, 10, 79–101. [Google Scholar] [CrossRef]
- Liu, J.; Wang, D.; Wang, H.; Yang, N.; Hou, J.; Lv, X.; Gong, L. Low frequency magnetic field assisted production of acidic protease by Aspergillus niger. Arch. Microbiol. 2024, 206, 273. [Google Scholar] [CrossRef]
- Mayura, V.; Nan-Nan, Y.; Sin-Jin, B.; Ikhwan, K. Enhancement oh fungal enzyme production by radio-frequency electromagnetic fields. J. Fungi 2022, 8, 1187. [Google Scholar] [CrossRef]
- Hashim, M.S. Effect of Static Magnetic Field on Amylase and Protease Produced by Some Fungal Isolates Using Solid State Fermentation. Master’s Thesis, Department of Biotechnology, College of Science, Al-Nahrain University, Baghdad, Iraq, 2016. Available online: https://www.nahrainuniv.edu.iq/sites/default/files/%D8%A7%D9%84%D8%A7%D8%B7%D8%B1%D9%88%D8%AD%D8%A9%20%D9%83%D8%A7%D9%85%D9%84%D8%A9.pdf (accessed on 23 October 2024).
- Aiman, M.A.; Abdul, G.I.Y.; Abdul, W.S.J. Effect of magnetic field energy on growth of Aspergillus flavus and aflatoxins production. J. Al-Nahrain Univ. 2013, 16, 180–187. [Google Scholar] [CrossRef]
- Chen, W.; Zhang, Y.; Shi, Z. Effect of extremely low frequency electromagnetic field on the pathogenicity of Magnaporthe oryzae. Sci. Total Environ. 2023, 870, 161939. [Google Scholar] [CrossRef] [PubMed]
- Sztafrowski, D.; Muraszko, J.; Jasiura, A.; Bryk, P.; Urbanek, A.K.; Krasowska, A. The alternating 50 Hz magnetic field depending on the hydrophobicity of the strain affects the viability, filamentation and sensitivity to drugs of Candida albicans. PLoS ONE 2023, 18, e0291438. [Google Scholar] [CrossRef] [PubMed]
- Cairns, T.C.; Zheng, X.; Zheng, P.; Sun, J.; Meyer, V. Turning inside out: Filamentous fungal secretion and its applications in biotechnology, agriculture, and the clinic. J. Fungi 2021, 7, 535. [Google Scholar] [CrossRef] [PubMed]
- Zhang, N.; Zhang, H.; Khan, L.A.; Jafari, G.; Eun, Y.; Membreno, E.; Gobel, V. The biosynthetic-secretory pathway, supplemented by recycling routes, determines epithelial membrane polarity. Sci. Adv. 2023, 9, 4620. [Google Scholar] [CrossRef]
- Jadhav, R.; Mach, R.L.; Mach-Aigner, A.R. Protein secretion and associated stress in industrially employed filamentous fungi. Appl. Microbiol. Biotechnol. 2024, 108, 92. [Google Scholar] [CrossRef]
- Shunk, G.K.; Gómez, X.R.; Averesch, N.J.H. A self-replicating radiation-shield for human deep-space exploration: Radiotrophic fungi can attenuate ionizing radiation aboard the international space station. BioRxiv 2020. [Google Scholar] [CrossRef]
Disclaimer/Publisher’s Note: The statements, opinions and data contained in all publications are solely those of the individual author(s) and contributor(s) and not of MDPI and/or the editor(s). MDPI and/or the editor(s) disclaim responsibility for any injury to people or property resulting from any ideas, methods, instructions or products referred to in the content. |
© 2025 by the authors. Licensee MDPI, Basel, Switzerland. This article is an open access article distributed under the terms and conditions of the Creative Commons Attribution (CC BY) license (https://creativecommons.org/licenses/by/4.0/).